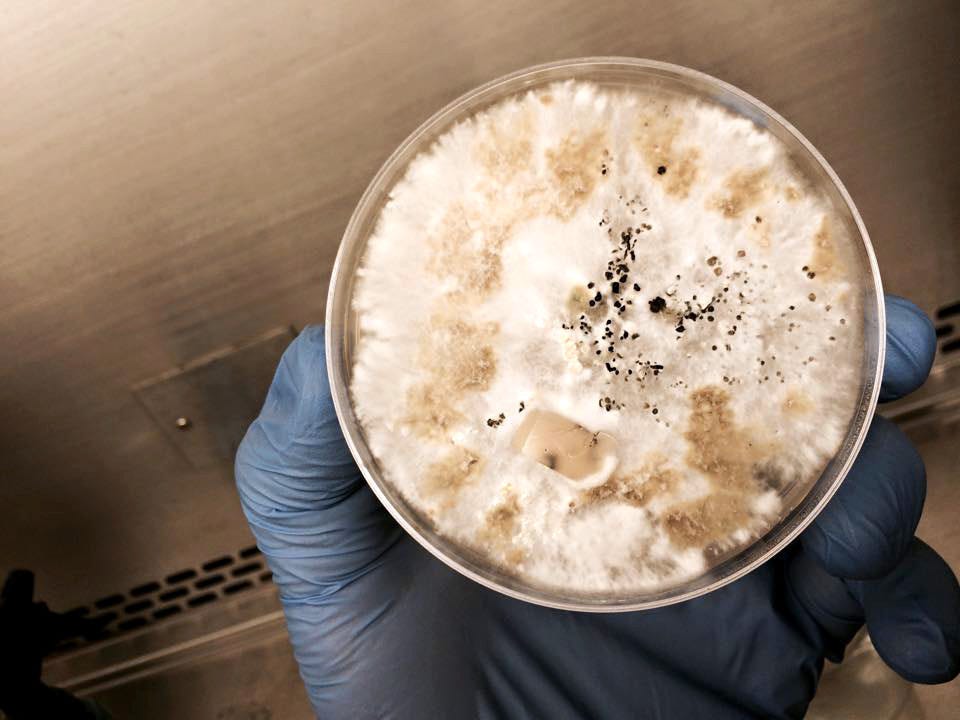

Need some good news?
An unexpected newsletter this week.
This week, I’m going a little off script—because sometimes, when the world feels heavy, we just need some good news. Not to distract us, or make us forget the pain—particularly that of the Palest*nian and Sud*nese people right now—but to remind us that when people work together, extraordinary things can happen.
And that nature truly is mother. (As is Ms Rachel.)
Namibia makes history and higher education free
Starting in 2026, Namibia will make higher education free by covering 100% of tuition and registration fees at all public universities and vocational training centres—a historic policy announced by President Netumbo Nandi-Ndaitwah, the country’s first female president.
Namibia has also made world history: it’s three highest offices—President, Vice President, and Speaker of the National Assembly—are now all held by women. The first country ever lead entirely by women.
Nature’s created a natural solution to plastic pollution
A fungus—called Pestalotiopsis microspora—discovered in part of the Amazon rainforest naturally digests and fully metabolises plastic. Found in Ecudaor’s Yasuni National Forest, the fungus can survive on polyurethane plastic alone, even without oxygen.
Most methods for plastic disposal merely break it into pieces, creating microplastics that end up everywhere (including in men’s testicles). However this fungus fully digests polyurethane plastic, offering a natural solution to plastic waste.
Being ordinary: the special secret for Dutch kids
Dutch kids have ranked number one in wellbeing for the past 15 years—a feat credited to the Dutch parenting approach. Their approach values being ordinary over exceptional; focusing on safety, space for play, and strong family connections, rather than packed schedules or a pressure to achieve.
Happiness, in this model, is something children carry rather than chase. Research supports the approach—showing that it’s not achievement that builds children’s confidence, but connection, autonomy, and a calm, supportive home (which the Dutch are evidently nailing).
A Zimbabwean all-women anti-poaching group reduced elephant poaching by 90%
In Zimbabwe, an all-women anti-poaching unit called Akashinga has slashed elephant poaching in the Lower Zambezi Valley by 90% since 2017.
Akashinga, meaning ‘The Brave Ones’ in Shona, is made up of women—many of whom are single mothers or survivors of domestic violence. Together, they have arrested more than 1,100 poachers, safeguarded wildlife, and channelled resources back into their communities. Goals.
Sweden turns trash into treasury funds
Sweden is so good at waste management they import other countries waste. With high recycling and composting rates, Sweden doesn’t generate enough waste to keep its plants busy—so it imports 1.3 million tonnes annually from countries such as the UK, Norway and Ireland (who all pay for the service).
Less than 1% of Sweden’s trash ends up in landfill, while around 50% of household waste is incinerated to provide electricity and heating for over a million homes, cutting the country’s reliance on fossil fuels.
THIS is an example of a circular economy—transforming waste into a valuable resource, while offering a model for sustainable waste management worldwide.
Ms Rachel gets the kudos she deserves
Ms Rachel, who’s been proudly and bravely vocal on behalf of Palest*nian and Sud*nese children, has been named one of Glamour’s Women of the Year and recognised by Rolling Stone as the third most influential creator for 2025.
Amongst the merciless criticism and backlash she’s receiving for believing children deserve basic human rights (!), this is public recognition of what a badass she is.
India’s farmers are healing the planet
Across India, farmers—who also happen to be women—are are the forefront of an ecological revolution. Using ancestral seed banks, they are building chemical-free farms that restore soil, protect biodiversity and challenge industrial agriculture.
But what they’re doing goes beyond food: they’re preserving culture, breaking gender norms, and showing that climate solutions can grow from the ground up.
Football fans keep flying the Palest*nian flag
Despite official restrictions, football fans across the globe—in Chile, Spain, France, the UK, and Scotland—continue to use the sport as a platform for Pal*stinian solidarity by displaying flags and banners in support of Palest*ne.
Sports are political. (Everything is political.)
One woman planted 2 million trees in the desert
Yi Jiefang, who is now 67 years old, has spent over a decade turning Inner Mongolia’s desert into a thriving forest, planting more than 2 million trees to honour her late son’s wish.
She planted 46 trees every hour for 10 hours per day for 12 years!! (Let that sink in.) Battling extreme conditions, her efforts have helped to combat desertification, restore biodiversity, and mitigate climate change.
And, finally, more kids are drawing women as scientists!
A study of children’s drawings shows real progress in how kids see scientists: more children are now imagining—and drawing—women in lab coats than ever before. A (hand drawn) sign that the future of science may be in women’s hands.
Feeling better? If so, here’s how you can take action to help end use collective power for good.
Normal writing will resume next week.